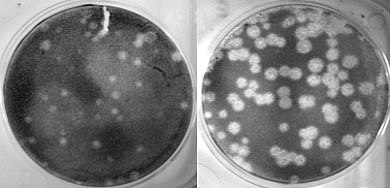
MUTACIONES

-
A finales de 1915 se vio un aumento del 75% de mortalidad causado por gripe respecto a 1914 en Estados Unidos
-
Se dan alrededor de 18.886 muertos por gripe, un 2,6 % de mortalidad, cuando una gripe estacional arrojaba en Estados Unidos una mortalidad media de un 0,056 %. Se además un aumento del 65% de mortalidad respecto a 1915 en Estados Unidos.
-
Se dan casos sin identificar en al menos 14 de los 16 campamentos militares estadounidenses esparcidos por todo el territorio nacional.
-
Se registran 12 muertos en Camp Pick por la gripe, sin embargo, no se ha reconocido como una pandemia.
-
Se registran 50 muertos en Camp Beauregart por la gripe, sin embargo, no se ha reconocido como una pandemia.
-
Se registran 172 muertos en Camp Bowie por la gripe. No se considera todavía una pandemia.
-
En Diciembre de 1917, se constatan 234 muertos de un total de 565 enfermos de gripe, todos ellos hombres jóvenes (esta cantidad supone un incremento entre 100 y 200 veces la tasa de mortalidad habitual para población juvenil). Se considera que fue en Camp Greene, cerca de Charlotte (Carolina del Norte), Estados Unidos donde apareció el paciente 0 infectado por el H1N1. Los síntomas descritos se diferencian de los de una gripe estacionaria para parecerse a los de una gripe pandémica.
-
A principios de 1918, se constata la pandemia por gripe y se determinan por primera vez los síntomas: cara con color grisáceo, pupilas moderadamente dilatadas, fiebre que supera los 39 grados, pulso rápido, superando las 140 pulsaciones por minuto incluso pudiendo llegar a las 160, respiración superficial y rápida y agotamiento extremo.
-
En Febrero de 1918, se suman más síntomas al monto anterior, entre ellos el dolor abdominal, hasta el punto de confundirse con una apendicitis, las pulsaciones aumentaban aún más en los casos de la segunda oleada, su color era todavía más pálido y el aspecto se asemejaba al de los enfermos por fiebres tifoideas.
-
La enfermedad fue notificada por primera vez en Fort Railey (Camp Funston) – Kansas, Estados Unidos.
-
Se localiza al paciente cero: Gilbert Michell (cocinero) en Fort Railey (Camp Funston) – Kansas, Estados Unidos.
-
Horas después de localizar al paciente cero, ya se contabilizaban decenas de casos, y se ve la necesidad de habilitar un hangar para los enfermos.
-
La gripe pasó al Reino Unido, después a Italia, más adelante cruzó a Alemania y por último a España.
-
Woodrow Wilson consultó con el general Peyton C. March si deberían suspender los envíos de tropas a Europa para no propagar la epidemia, pero March le indicó que una noticia así podía perjudicar mucho la marcha en el frente al saber la Triple Alianza los problemas entre las filas de su enemigo. Por esta razón Wilson no detuvo los envíos, pese a llegarle informes de que sus ciudadanos estaban enfermando e incluso muriendo en los barcos al declararse la gripe a bordo.
-
En el frente, la ofensiva de 1918 se suspendió por el ejército alemán porque tenía a un millón de soldados enfermos.
-
En la oleada de mayo de 1918, se cree que más de la mitad de la población de Madrid había contraído la enfermedad.
-
El virus sufre un grupo de mutaciones, convirtiéndose en un agente infeccioso letal.
-
Son cerca de un millón y medio de soldados estadounidenses desplazados a Europa, muchos enfermos de gripe.
-
Primera caso confirmado de la mutación en Brest, Francia; puerto por el que entraba la mitad de las tropas estadounidenses.
-
Pese a todo lo peor estaba por llegar. Aunque ciudades como Madrid habían pasado lo más duro, la segunda oleada de 1918 afectó tanto a las ciudades como a pequeños municipios del mundo rural. El 75 % de las muertes se cree que acontecieron en la segunda oleada de 1918.
-
En 1919 la enfermedad ya fue mucho menos virulenta por estar la mayoría de los organismos adaptados al virus.
-
Finalmente, en 1920 aún se detectó un último repunte, pero no hubo más. Sin embargo, los efectos negativos sobre la población siguieron produciéndose en forma de mortalidad infantil al perder los niños a uno de los dos progenitores y en algunos casos a los dos. Con todo, la gran epidemia de la gripe desapareció de una forma muy parecida a como había empezado, entre otras razones por estar la mayoría de los supervivientes inmunizados.
-
Se dice, que la gripe española dejó un estimado de 50-100 millones de fallecidos y un total de 500 millones de casos confirmados; siendo esta pandemia, la más mortal y agresiva en la historia de la humanidad.
A list shows items. A timeline shows sequence.
Use Timetoast to make dates, milestones, and turning points easier to understand in a clear visual format. Timetoast is a timeline maker for work, school, research, and stories.